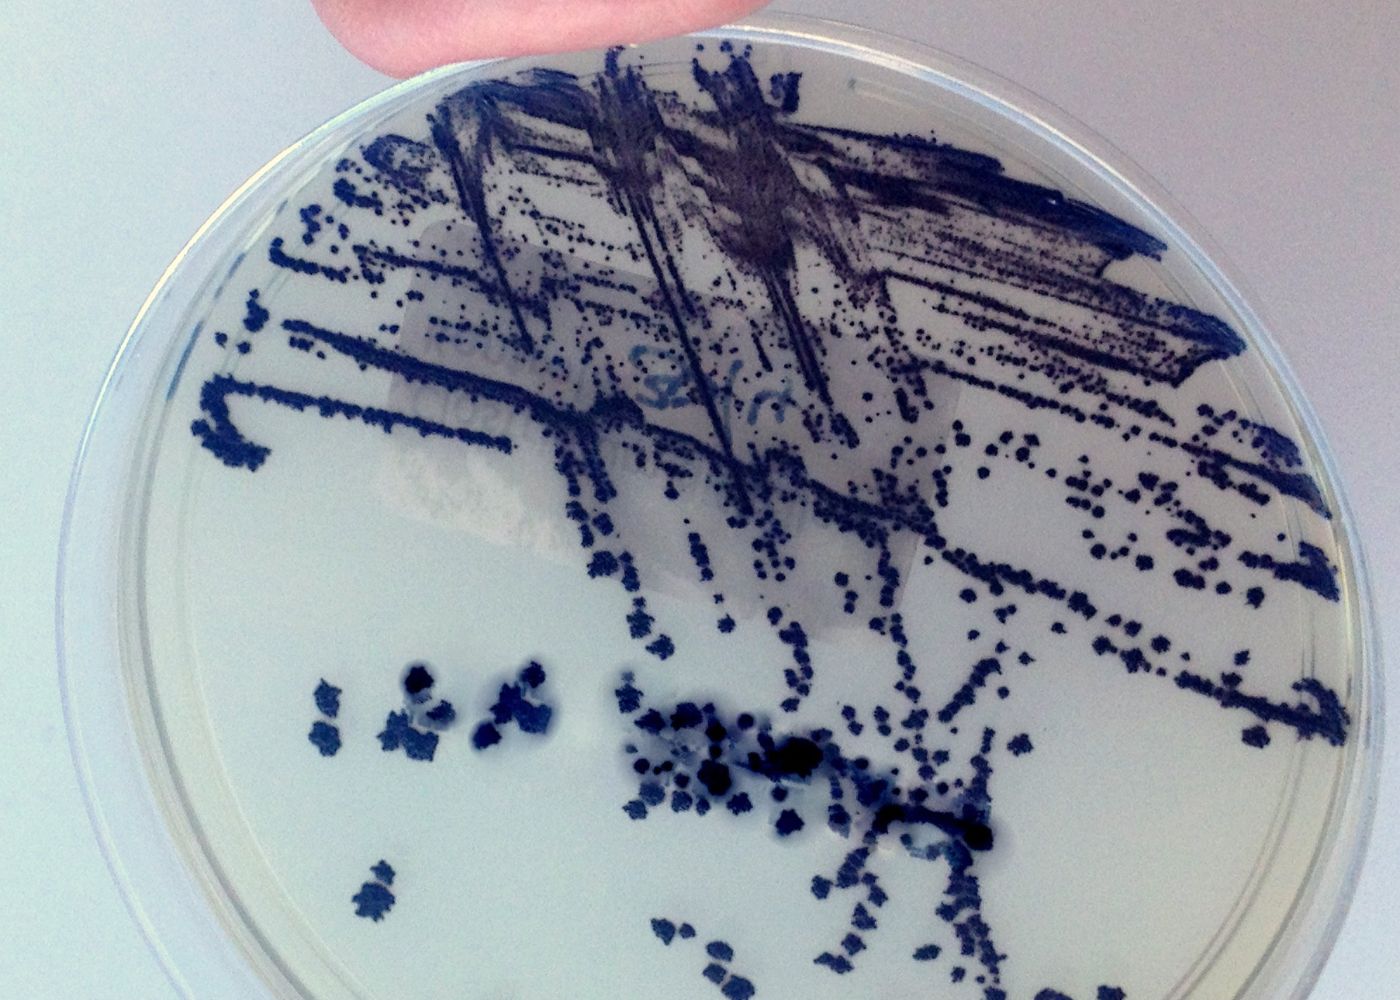

CLOSTRIDIUM DIFFICILE TOXINA A Y B
Detecta la presencia de estas toxinas en una muestra de heces. Estas toxinas son producidas por la bacteria Clostridioides difficile (anteriormente Clostridium difficile) y pueden causar diarrea e inflamación del colon (colitis) en los humanos, especialmente en personas que han tomado antibióticos recientemente.
Detalles de análisis
Indicaciones
(Ayuno no necesario) Solo se recibirá muestra en recipiente adecuado de plástico o pañal con heces recientes.
Procedimiento
Recolectar Heces recientes del tamaño de una nuez.
Tiempo de entrega
2 a 3 días hábiles.
Genetic Testing
¿Tienes alguna duda?
Consulta las dudas más frecuentes o comunicate con nosotros para una mejor atención
Trabajamos con la mejor tecnología y equipo para brindarte resultados certeros.
Te recomendamos acudir con tu médico para que interprete tus resultados en el contexto de tu salud. También puedes contactarnos si tienes dudas generales; nuestro equipo estará encantado de ayudarte a entender el proceso.
No siempre es necesaria una orden médica. Puedes acudir directamente para realizarte estudios básicos o de rutina. Sin embargo, algunos análisis especializados sí requieren indicación médica.